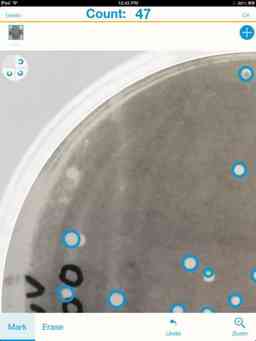
Thumbnail 3
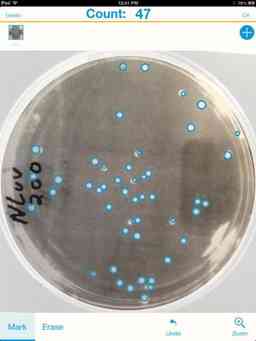
Thumbnail 2
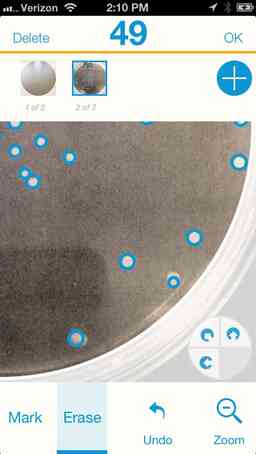
Thumbnail 4
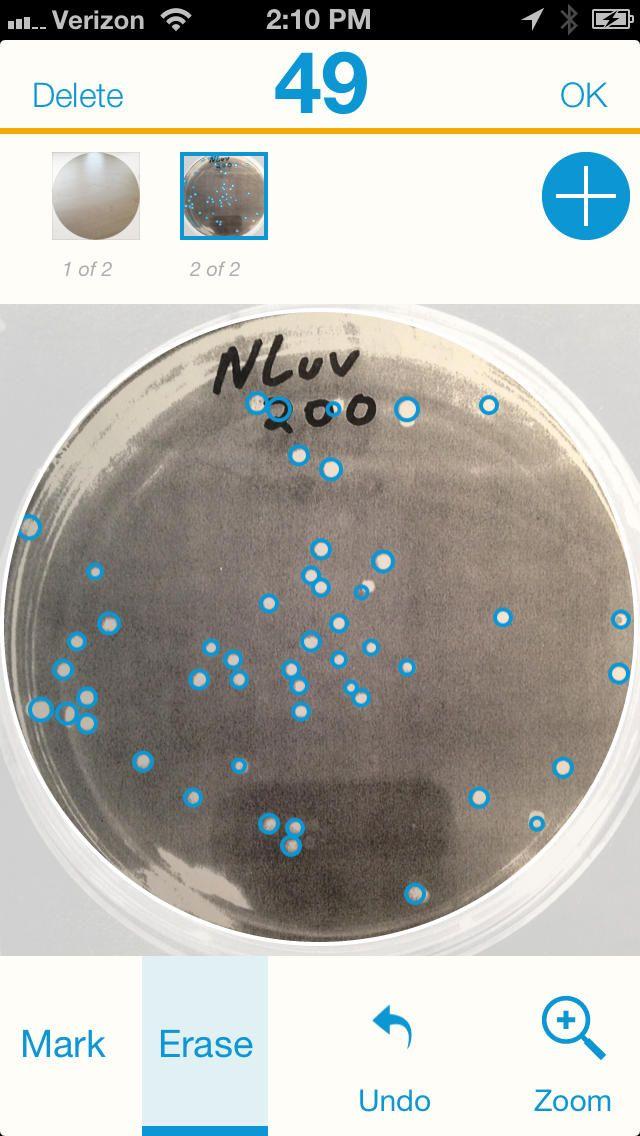
Image 1

What is Promega Colony Counter?
The Colony Counter app revolutionizes the tedious process of counting bacterial colonies on agar plates. By allowing users to take photographs of their plates directly from their smartphones, this innovative solution enables efficient colony enumeration without the need to be physically present in the lab. The app's sophisticated image analysis algorithms provide an initial colony count estimate, which users can then manually refine to ensure accuracy. This feature allows for a seamless workflow, where researchers can review and analyze their plate data at their convenience, without being confined to the lab. Furthermore, the app facilitates the storage and comparison of individual plates or entire sets, empowering users to track their experimental progress and make data-driven decisions with ease
Highlights
- Smartphone-based colony counting: Capture plate images directly from your mobile device for off-site analysis
- Automated count estimation: Leverage advanced image processing to obtain an initial colony count estimate
- Manual refinement: Refine the automated count to ensure precise colony enumeration
- Plate storage and comparison: Save individual plates or complete sets for later review and comparison.
Platforms
- iPad
- iPhone
Languages
- English